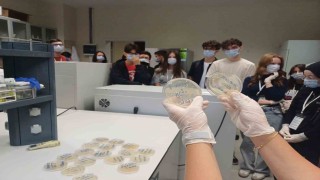
Öğrenciler iklim değişikliğinin etkilerini matematikle öğrendi

Harun çınar
Eskişehir’de akrabası tarafından tüfekle vurulan 30 yaşındaki adam, ilk verdiği "Kendimi vurdum" ifadesini değiştirip, ilgisizlikten dolayı amcasının oğlu hakkında dava açtı. Vurduğu akrabasına ihtiyaçları için yaklaşık 300 bin lira gönderen şahıs da, iddiaya göre hakkında dava açılması üzerine karşı icra dava açtı.
Eskişehir’de yaşayan 30 yaşındaki evli ve 3 çocuk babası Harun Çınar’ın başına geçtiğimiz ocak ayında talihsiz bir olay geldi. Çınar’ın iddiasına göre, amcasının oğlu Ş.Ç. sosyal medya hesabından moralinin bozuk olduğuna dair paylaşım yaptı. Akrabasının, Tepebaşı ilçesinin kırsal Danışment Mahallesi’nde bulunan evde 2 arkadaşlarıyla birlikte alkol aldığını öğrendi. Akrabasını merak eden Çınar, onun bulunduğu yere giderek alkollü amcasının oğlunu kent merkezine götürmeyi teklif etti. Daha sonra Harun Çınar’ın aracına binen Ş.Ç., köyden çıktıktan sonra araçtan inmek istedi. Bahse konu noktanın da oldukça ıssız olduğunu hatırlatan Harun Çınar, akrabasını bırakmak istemedi. Sert bir şekilde çıkış yapan Ş.Ç., aracı durdurmazsa onu yanındaki tüfekle vuracağını söyledi. Bunu ciddiye almayan Harun Çınar, ısrar sonrası durdu. İddiasına göre tüfeğiyle araçtan inen Ş.Ç., kendisine gitmemesi yönünde ısrar eden amcasının oğlu Harun Çınar’a tüfeği ile 2 el ateş etti. Fişeklerden biri isabet almazken, diğeri Çınar’ın sol bacağını deldi. Kanaması başlayan Harun Çınar, tişörtü ile bacağını bağlayarak kanamayı azaltmaya çalıştı. O sırada yaptığından pişman olan Ş.Ç.’ye kendisini hastaneye götürmesini rica etti. Ş.Ç. tarafından Yunus Emre Devlet Hastanesi’ne getirilen Harun Çınar burada tedavi altına alındı. Harun Çınar, evli ve 3 çocuk sahibi akrabasını korumak için tedavisi sürerken "Kendimi vurdum" yazılı ifadeye imza attı. Şüpheli Ş.Ç. de pişman olduğunu belirterek tedavisi için amcasının oğluna, açıklama bölümüne ’Borç’ yazarak banka havalesi ortalama 300 bin lira gönderdi.
"Amcasının oğluna icra davası açtı"
Bacağındaki sinirler ciddi hasar alan, akabinde aylarca yatağa bağlı kalan Harun Çınar, iddiasına göre kendisini vuran amca oğlunun "Geçmiş olsun" diyerek dahi aramadığını belirtti. Buna oldukça içerleyen ve belediyedeki işinden ayağındaki sorun nedeniyle başka bir pozisyona geçirilen, ayağında hissizlik oluşan ve yardım almadan yürüyemeyen Çınar, akrabasıyla kendisiyle ilgilenmediği için ifadesini değiştirip Ş.Ç. hakkında dava açtı. Kendisine dava açıldığını öğrenen şüpheli ise verdiği 240 bin TL’nin borç olduğunu belirterek, iddiaya göre vurduğu amcasının oğlu Harun Çınar’a icra davası açtı.
"Kafasını yerlere vurmaya başladı"
Olay gününü anlatan Harun Çınar, "Amcaoğlum Ş.Ç., Danışment köyünde oturup içerlerken WhatsApp grubundan mesaj atmış, kötüyüm diye. Ben de yanına gittim sohbet etmek, muhabbet etmek için. Onlar içmiş, alkolü fazla kaçırmışlar. Ondan sonra elinde bir silah vardı, ava gidelim falan diyorlardı. Tüfek vardı. Yarım saat falan bir muhabbet oldu. Sonra vazgeçtiler, çıktık oradan. Ben sarhoş diye arabayla evine götüreyim bırakayım dedim. Danışment köyünden çıkışında tam giderken yolda ’seni vuracağım’ diye söylemlerde bulundu. Seyir halinde iken ’ineceğim ben burada’ dedi. Ben de ’evine götüreyim seni’ dedi. Konuşma esnasında 2-3 defa beni vuracağını söyledi. Arabayı durdurdum, arkasına geçtiğimizde tekrardan ’abi gel evine götüreyim’ dedikçe beni vuracağını söyledi, ben de şaka yapıyor zannettim ve ’vurursan vur’ dedim. Arkaya adım attım arabaya doğru. İki silah sesi duydum. Ondan sonra orada yere düştüm. Kanlar fışkırmaya başladı zaten. İlk önce üstümdeki tişörtü çıkarttım, turnike yaptım bacağıma. Ondan sonra yanımda gelip ’teslim olacağım’ diye kafasını yerlere vurmaya başladı. Kendisine ’abi beni hastaneye götür. İlk önce beni götür, sonra teslim olacaksan ol, ne yapacaksan yap dedim’" diye konuştu.
"Hem vurdu, vurduktan sonra icra yolladı"
Akrabasını ilgisizliğinden dolayı şikayet ettiği için onun da kendisine icra davası açtığını iddia eden Çınar, "Yunus Emre Devlet Hastanesi’ne götürdü beni. Orada baygın olduğum halde bir tane ifade getirdiler işte. ’Şikayetçi olamayacak mısın’ dediler. Ben de 3 çocuğu var diye onu korumak için ’olmayacağım’ dedim. Tedavim için bankadan bana 300 bin lira gönderdi ve dekonta borç yazmış. Sağlık durumum bozulunca ve benimle ilgilenmeyince ifademi değiştirip dava açtım. Kaynakçıydım mesleğimden de oldum. Sağlığım bozuldu, çocuğumu kucağına alamıyorum, götüremiyorum. Günde belki iki üç kere yere düşüyorum. Kiramı verdiği için bana icra göndermiş paraları almaya. Ben zaten en başında gördüm. Dekontlarda altına borç yazmışlar. Zaten her şeyi planlamışlar. Hem vurdu, vurduktan sonra icra yolladı" ifadelerini kullandı.
"Karşı tarafın kötü niyeti ortada"
Harun Çınar’ın avukatı Burak Aladere ise konuyla ilgili olarak, "Müvekkilim bacağından ciddi şekilde yaralanıyor. Şu anda ayakta zar zor duruyor. Şahıs, sinir krizi geçiriyor. ’Ben ne yaptım, bundan sonra çocuklarımın yüzüne nasıl bakacağım, cezaevine düşeceğim’ gibi bir sinir krizi geçiriyor. Müvekkil de ’Abi sırası değil, hastaneye gitmem gerekiyor, çok kan kaybediyorum’ diyor. Sonrasında şahıs müvekkili burada hastaneye yetiştiriyor. Bu esnada müvekkil tabii ki çok fazla kan kaybettiği için alınan ifadesindeki beyanları okuma şansı olmaksızın beyanı imzalıyor. Daha sonrasında öğreniyor ki sanki kendi kendisine vurmuş gibi bir beyan imzalatılıyor müvekkile. Aynı zamanda da şahıslar, müvekkili vuran şahıslar uzun bir süre müvekkile şikayetçi olmaması konusunda telkinlerde bulunuyorlar. Hatta yeri geliyor evine gelerek baskı yapıyorlar, para teklif ediyorlar. Yaklaşık 300 bin lira gibi bir rakam aslında müvekkile borç açıklamasıyla ödeniyor. Sonrasında biz şikayetimizi yaptıktan sonra da karşı taraf bu borç açıklamasıyla gönderildiğini ileri sürerek müvekkilden bu ödediği paraların iadesi için bir icra takibi de başlattı. Biz bu icra takibine de itiraz ettik. Karşı tarafın kötü niyeti ortada. Umuyorum ki soruşturma içerisinde gerekli cezayı alacaktır" dedi.

Yorum Yazın